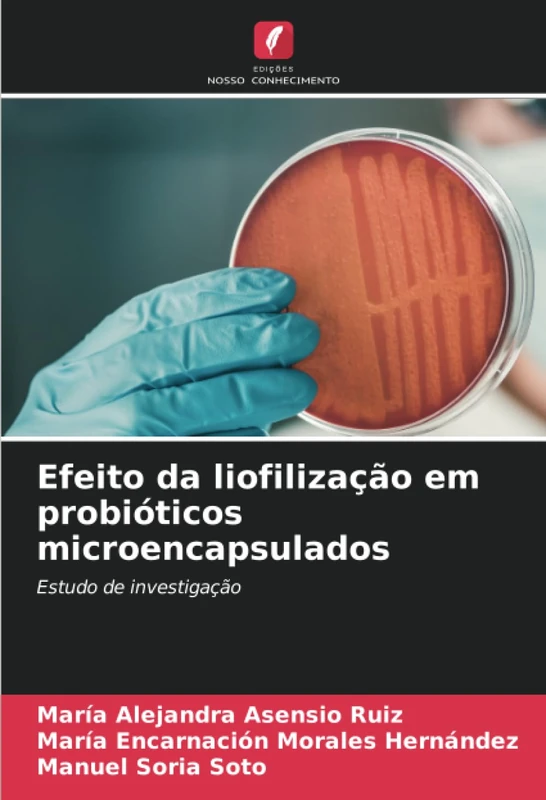
Efeito da liofilização em probióticos microencapsulados: Estudo de investigação

We can't find the internet
Attempting to reconnect
Something went wrong!
Hang in there while we get back on track

£55.00
Avaliação das propriedades de virulência e caraterização de Aeromonas: Aeromonas no ambiente
Price data last checked 69 day(s) ago - refreshing...
We'll watch every seller, every day. One email when your price arrives.
It has never been this cheap. We have no record of a lower price.
£55 today · cheaper than every other day in the last 3 months
NEW HERE?
Amazon shows you one price. We show you all of them.
Tosheroon watches Amazon prices so you don't have to. Every product on Amazon has a price history — we make it visible. Set the price you'd actually pay, and we'll email you the second it gets there. No app, no account, one email.
WHAT'S ON THIS PAGE
when this has been cheap or pricey
where the price is heading next
all-time high & low, recent range
name your number, we'll email you
Price History & Forecast
Grey patches = out of stock. Cheaper = lower on the chart. Hover for exact prices.
Last 22 days • 22 data points (No recent data available)
Price Distribution
Price distribution over 22 days • 1 price levels
Price Analysis
Most common price: £55 (22 days, 100.0%)
Price range: £55 - £55
Price levels: 1 different prices over 22 days
Product Specifications
- Format
- paperback
- ASIN
- 6208096782
- Domain
- Amazon UK
- Release Date
- 17 September 2024
- Listed Since
- 18 September 2024
Barcode
No barcode data available
Similar Products You Might Like

Deteção molecular de genes de resistência à tetraciclina em Aeromonas

Estudos in silico e ADMET: de Compostos de Imidazol e Quinolona para o seu Potencial Antimicrobiano

Capacidade de promoção do crescimento de endófitos bacterianos em S. melongena L.

Ilhas de patogenicidade bacteriana

Avanços em Microbiologia

Avaliação da Probabilidade Curativa dos Metabolitos Bioactivos

Antibacteriano e Fitoquímico Propriedades das Plantas

Cálculo das percentagens - diferenciação e individualização

Desenvolvimento e avaliação do impacto dos polibioinoculantes

Polimorfismos de genes em microrganismos

Detecção de biomarcadores de poluição por mercúrio em sargos-amarelos

O desempenho financeiro dos critérios de convergência na zona UEMOA

Microbiologia ambiental: Bio-remediação de resíduos da indústria de lacticínios

Eflorescência Tenores na Educação

Degradação da celulose por Actinomiceto de Eisenia foetida

Impacto dos metais pesados na variação genética das espécies Coelatura

CARACTERIZAÇÃO DE "LOBOS SOLITÁRIOS": Tipologias

Análise da murchidão fúngica na ervilha-de-angola

Complexo promotor da anáfase: estrutura e expressão

GESTÃO DE BIORISCOS NO QUÉNIA: Percepções, conhecimentos e sensibilização

Expressão apoptótica de Bax e proliferativa de PCNA no adenoma pleomórfico

Microbiologia endodôntica
Efeito da liofilização em probióticos microencapsulados: Estudo de investigação
